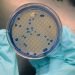
खानेपानीमा अत्यधिक ‘कोलीफर्म’ भेटियो

काठमाडौं । आईपीएल स्टारहरुले भरिएको भारत आफ्नो २ सयौं टी-ट्वान्टी अन्तर्राष्ट्रियमा वेस्ट इन्डिजसँग ४ रनले पराजित भएको छ ।
भ्रमण टोलीलाई पराजित गरेसँगै वेस्ट इन्डिजले पाँच खेलको टी-ट्वान्टी आई सिरिजमा १-० को अग्रता बनाएको छ ।
ब्रायन लारा क्रिकेट स्टेडियममा सम्पन्न खेलमा टस जितेर पहिला ब्याटिङ रोजेको वेस् टइन्डिजले निर्धारित २० ओभरमा ६ विकेट गुमाउँदै १ सय ४९ रन बनाएको थियो ।
वेस्ट इन्डिजका कप्तान रोभम्यान पावेलले सर्वाधिक ४८ रनको योगदान दिए । निकोलश पुरन ४१ र ब्रेन्डन किंग २८ रनमा आउट भए । भारतका युजभेन्द्र चाहल र अर्शदीप सिंहले समान २(२ विकेट लिए ।
जितको लागि १ सय ५० रनको विजयी लक्ष्य पछ्याएको भारतले निर्धारित २० ओभरमा ९ विकेट गुमाउँदै १ सय ४५ रन मात्र बनाउन सक्यो ।
भारतका लागि डेब्यू खेल खेलेका ब्याटर तिलक बर्माले सर्वाधिक ३९ रन बनाए । सूर्यकुमार यादव २१ र कप्तान हार्दिक पाण्डेयले १९ रन बनाए ।
वेस्ट इन्डिजलाई नाटकीय जित दिलाउन रोमारियो शेफर्ड, जेसन होल्डर र ओबेद म्याककोयले समान २(२ विकेट लिए । दुई देशबीचको दोस्रो टी(ट्वन्टी आई आइतबार खेलिने छ ।